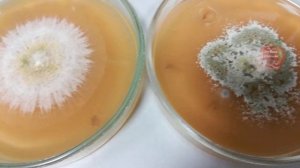
ДВА ПОЛИВА ЭТИМ ПРОСТЫМ ОТВАРОМ ОБЕСПЕЧИТ РОСТ ЗДОРОВОЙ,ТОЛСТЕНЬКОЙ  РАССАДЫ.ЗАЛОГ ОГРОМНОГО УРОЖАЯ

0:53
0:53
2023-09-02 21:28

 1:44
1:44

 1:44
1:44
2024-03-06 16:59

 5:32
5:32

 5:32
5:32
2017-05-30 15:53

 3:51
3:51

 3:51
3:51
2023-08-14 17:42

 3:30
3:30

 3:30
3:30
2023-08-14 09:12

 3:25
3:25
3:25
3:25
2023-09-04 10:45

 1:56:57
1:56:57

 1:56:57
1:56:57
2026-04-19 21:00

 2:49:04
2:49:04

 2:49:04
2:49:04
2026-04-23 12:28

 1:20:20
1:20:20

 1:20:20
1:20:20
2026-04-24 11:27

 3:12:39
3:12:39

 3:12:39
3:12:39
2026-04-02 00:05

 2:36:33
2:36:33

 2:36:33
2:36:33
2026-04-24 17:06

 3:01:31
3:01:31

 3:01:31
3:01:31
2025-10-02 19:15

 1:49:24
1:49:24

 1:49:24
1:49:24
2024-10-26 19:12

 2:28:08
2:28:08

 2:28:08
2:28:08
2026-04-24 17:11

 3:00:33
3:00:33

 3:00:33
3:00:33
2025-04-06 21:40

 2:29:19
2:29:19

 2:29:19
2:29:19
2025-10-01 19:29

 2:40:57
2:40:57

 2:40:57
2:40:57
2025-12-17 16:07

 2:57:10
2:57:10
![Пропаганда - Рейв (Премьера клипа 2026)]() 2:49
2:49
![AzaLi - Стерва (Премьера клипа 2026)]() 2:19
2:19
![NITI DILA - Здесь хорошо (Премьера клипа 2026)]() 2:09
2:09
![Рустам Нахушев - Гуляй (Премьера клипа 2026)]() 3:20
3:20
![Игорь Кибирев - Уйду в туман (Премьера клипа 2026)]() 3:50
3:50
![Ahmed Shad - Пьяными (Премьера клипа 2026)]() 2:18
2:18
![Инна Вальтер - Больше не боюсь (Премьера клипа 2026)]() 3:17
3:17
![Нурбек Махмудов - Кечир юрак (Премьера клипа 2026)]() 3:57
3:57
![SEREBRO - Кто я для тебя (Премьера клипа 2026)]() 3:15
3:15
![Ислам Итляшев - Пиранья любовь (Премьера клипа 2026)]() 2:52
2:52
![Гайратжон Янгибоев & Бонухон - Шахарда (Премьера клипа 2026)]() 3:15
3:15
![Артур Пирожков - Самый красивый (Премьера клипа 2026)]() 2:16
2:16
![BEARWOLF - Феникс (Премьера клипа 2026)]() 3:32
3:32
![Tural Everest - Блестящая (Премьера клипа 2026)]() 2:44
2:44
![AY YOLA - Aihylyu (Премьера клипа 2026)]() 3:49
3:49
![NAIMAN - На волне (Премьера клипа 2026)]() 2:13
2:13
![Мужик из Сибири (Александр Конев) - Хотеть не вредно (Премьера клипа 2026)]() 2:31
2:31
![Рейсан Магомедкеримов - Холостой (Премьера клипа 2026)]() 2:22
2:22
![Ярослав Леонов - Королева весны (Премьера 2026)]() 3:45
3:45
![Сергей Завьялов - А ты не мучай (Премьера клипа 2026)]() 2:45
2:45
![Шары ввех | Balls Up (2026)]() 1:46:45
1:46:45
![Грозовой перевал | Wuthering Heights (2026)]() 2:16:14
2:16:14
![Хамнет: История, вдохновившая «Гамлета» | Hamnet (2025)]() 2:05:47
2:05:47
![Зомби по имени Шон | Shaun of the Dead (2004)]() 1:39:31
1:39:31
![Примат | Primate (2025)]() 1:32:12
1:32:12
![Обитель зла: Возмездие | Resident Evil: Retribution (2012)]() 1:35:41
1:35:41
![GOAT: Мечтай по-крупному | GOAT (2026)]() 1:39:46
1:39:46
![Спрингстин. Избавь меня от небытия | Springsteen: Deliver Me from Nowhere (2025)]() 1:59:36
1:59:36
![Крик 7 | Scream 7 (2026)]() 1:53:59
1:53:59
![Невеста! | The Bride! (2026)]() 2:06:44
2:06:44
![Я иду искать 2 | Ready or Not 2: Here I Come (2026)]() 1:47:56
1:47:56
![Обитель зла 3 | Resident Evil: Extinction (2010)]() 1:34:09
1:34:09
![Завещание Анны Ли | The Testament of Ann Lee (2025)]() 2:16:48
2:16:48
![На помощь! | Send Help (2026)]() 1:52:59
1:52:59
![Давид | David (2025)]() 1:49:18
1:49:18
![Грандиозная подделка | Il falsario (2025)]() 1:55:41
1:55:41
![Военная машина | War Machine (2026)]() 1:49:24
1:49:24
![Сестра | Siseuteo (2026)]() 1:26:45
1:26:45
![28 лет спустя: Часть II. Храм костей | 28 Years Later: The Bone Temple (2026)]() 1:49:24
1:49:24
![Майк и Ник и Ник и Элис | Mike & Nick & Nick & Alice (2026)]() 1:47:10
1:47:10
![Тёплая анимация | Новая авторская анимация Союзмультфильма]() 6:46
6:46
![Мартышкины]() 7:10
7:10
![Шахерезада. Нерассказанные истории Сезон 1]() 23:53
23:53
![Умка]() 7:11
7:11
![Зомби Дамб]() 5:14
5:14
![Пиратская школа]() 11:06
11:06
![Корги по имени Моко. Волшебный мир снов]() 8:60
8:60
![Майло]() 0:25
0:25
![Зебра в клеточку]() 6:30
6:30
![Синдбад и семь галактик Сезон 1]() 10:23
10:23
![Простоквашино]() 7:19
7:19
![Мультфильмы военных лет | Специальный проект к 80-летию Победы]() 7:20
7:20
![Мотофайтеры]() 13:10
13:10
![Команда Дино. Исследователи Сезон 2]() 13:26
13:26
![Тайны Медовой долины]() 7:01
7:01
![Пакман в мире привидений]() 21:37
21:37
![Пластилинки]() 25:31
25:31
![Чемпионы]() 7:33
7:33
![Супер Дино]() 12:41
12:41
![Команда Дино Сезон 1]() 12:08
12:08
![Сборник Топ 20 Номеров за 2024 год - Уральские Пельмени]() 2:52:30
2:52:30
![ХИТЫ 2025 ТАНЦЕВАЛЬНАЯ МУЗЫКА СБОРНИК]() 1:41:18
1:41:18
![28 лет спустя: Часть II. Храм костей | 28 Years Later: The Bone Temple (2026)]() 1:49:24
1:49:24
![СваТы 1 сезон(все серии)]() 2:17:36
2:17:36
![Аватар 3: Пламя и пепел фильм, 2025]() 3:09:06
3:09:06
![Кей-поп-охотницы на демонов | KPop Demon Hunters (2025)]() 1:39:41
1:39:41
![Jakone и Kiliana - Асфальт (Mood Video)]() 2:50
2:50
![Гордость и предубеждение | Pride & Prejudice (2005)]() 2:08:21
2:08:21
![Инна Вальтер - Дымом лечилась (Исповедь хулиганки)]() 7:04
7:04
![Три Кота 🐱 Сборник серий подряд | Смотреть онлайн развивающие мультики и игры для детей и малышей]() 3:16:51
3:16:51
![Дьявол носит Prada | The Devil Wears Prada (2006)]() 1:49:29
1:49:29
![Барбоскины. Сезон 1. Серия 1. Пчёлка]() 5:38
5:38
![Сборник Новогодних Номеров 2024 - Уральские Пельмени]() 3:18:51
3:18:51
![Буба - Все серии]() 3:06:34
3:06:34
![Пять ночей с Фредди 2 | Five Nights at Freddy's 2 (2025)]() 1:44:11
1:44:11
![Аватар: Путь воды (2022)]() 3:12:39
3:12:39
![Bakhtin - Целовала (Премьера клипа 2023)]() 3:16
3:16
![Ми–Ми–Мишки 💫 Звездная история 🙃 Все серии ✨ Мультики для детей]() 2:10:31
2:10:31
![Ми–Ми–Мишки 💫 Звездная история 🙃 Все серии ✨ Мультики для детей]() 2:10:31
2:10:31
![Смешарики (большой сборник)]() 3:25:27
3:25:27

 2:57:10
2:57:10Скачать Видео с Рутуба / RuTube
| 426x240 | ||
| 640x360 | ||
| 1280x720 | ||
| 1920x1080 |
 2:49
2:49
2026-04-17 12:23
 2:19
2:19
2026-04-23 11:42
 2:09
2:09
2026-04-10 09:36
 3:20
3:20
2026-04-25 16:09
 3:50
3:50
2026-04-21 10:26
 2:18
2:18
2026-04-01 15:10
 3:17
3:17
2026-04-02 08:36
 3:57
3:57
2026-04-20 16:53
 3:15
3:15
2026-04-03 09:24
2026-04-23 10:50
 3:15
3:15
2026-04-20 17:02
 2:16
2:16
2026-04-20 16:39
 3:32
3:32
2026-04-15 12:36
 2:44
2:44
2026-04-10 09:57
 3:49
3:49
2026-04-20 16:46
 2:13
2:13
2026-04-14 08:26
 2:31
2:31
2026-04-08 11:47
 2:22
2:22
2026-04-11 10:26
 3:45
3:45
2026-04-01 14:58
 2:45
2:45
2026-04-23 11:37
0/0
 1:46:45
1:46:45
2026-04-22 00:25
 2:16:14
2:16:14
2026-04-20 11:54
 2:05:47
2:05:47
2026-02-06 18:40
 1:39:31
1:39:31
2026-02-16 01:07
 1:32:12
1:32:12
2026-02-17 21:38
 1:35:41
1:35:41
2026-02-25 19:41
 1:39:46
1:39:46
2026-03-27 02:41
 1:59:36
1:59:36
2026-02-13 14:02
 1:53:59
1:53:59
2026-04-22 11:21
 2:06:44
2:06:44
2026-04-22 11:21
 1:47:56
1:47:56
2026-04-12 17:20
 1:34:09
1:34:09
2026-02-25 19:41
 2:16:48
2:16:48
2026-03-12 23:31
 1:52:59
1:52:59
2026-03-27 14:10
 1:49:18
1:49:18
2026-01-29 11:25
 1:55:41
1:55:41
2026-02-26 14:41
 1:49:24
1:49:24
2026-03-10 12:44
 1:26:45
1:26:45
2026-03-27 13:34
 1:49:24
1:49:24
2026-02-19 14:08
 1:47:10
1:47:10
2026-04-03 12:10
0/0
 6:46
6:46
2026-04-25 14:53
 7:10
7:10
2025-12-30 18:33
2021-09-22 23:25
 7:11
7:11
2026-01-20 10:00
 5:14
5:14
2024-11-28 13:12
 11:06
11:06
2022-04-01 15:56
 8:60
8:60
2025-12-09 11:58
 0:25
0:25
2026-04-10 13:19
 6:30
6:30
2022-03-31 13:09
2021-09-22 23:09
 7:19
7:19
2026-04-03 10:14
 7:20
7:20
2025-05-03 12:34
 13:10
13:10
2024-11-27 14:57
2021-09-22 22:54
 7:01
7:01
2022-03-30 17:25
 21:37
21:37
2024-11-28 17:35
 25:31
25:31
2022-04-01 14:30
 7:33
7:33
2026-04-15 17:25
 12:41
12:41
2024-11-28 12:54
2021-09-22 22:29
0/0
2025-01-13 14:00
2024-06-25 00:21
 1:49:24
1:49:24
2026-02-19 14:08
 2:17:36
2:17:36
2025-07-24 20:55
2025-12-26 16:56
 1:39:41
1:39:41
2025-10-29 16:30
 2:50
2:50
2024-07-04 15:48
 2:08:21
2:08:21
2023-05-03 20:56
 7:04
7:04
2018-07-11 11:26
 3:16:51
3:16:51
2025-10-03 19:48
 1:49:29
1:49:29
2023-04-27 15:40
 5:38
5:38
2023-12-25 15:26
2024-12-31 14:00
2024-10-24 16:05
 1:44:11
1:44:11
2025-12-25 22:29
2025-06-17 19:00
 3:16
3:16
2023-10-13 14:26
2024-01-17 17:34
2024-01-17 17:34
2025-01-24 05:04
0/0

